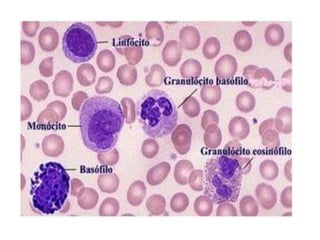
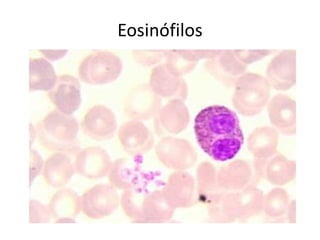
Eosinófilos

Este documento fornece um resumo sobre a interpretação do hemograma, incluindo as principais células do sangue estudadas (eritrócitos, leucócitos e plaquetas) e o que cada parte do exame (eritrograma, leucograma) pode indicar sobre a saúde do paciente, como anemias ou processos infecciosos.